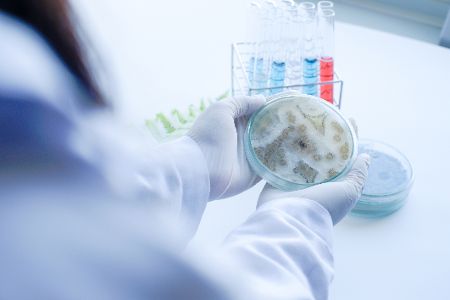
pilze in petrischale

Bauteile aus elektrischen Geräten könnten künftig auf Basis von Pilzmyzel hergestellt werden, was Millionen Tonnen Elektroschrott einsparen würde. Text: bearbeitet durch freenet (mehr Infos)

Bauteile aus elektrischen Geräten könnten künftig auf Basis von Pilzmyzel hergestellt werden, was Millionen Tonnen Elektroschrott einsparen würde. Text: bearbeitet durch freenet (mehr Infos)

Das Material aus Pilzmyzel ist stabil und biologisch abbaubar, was es zu einer umweltfreundlichen Alternative macht.

An der Johannes-Kepler-Universität Linz wird das Konzept der Elektronik auf Basis von Pilzmyzel intensiv geprüft.

Flexible Leiterplatten (FlexPCBs) stellen ein besonderes Problem dar, da für sie bisher keine biologisch abbaubaren Lösungen existieren.

Das Projekt "MycoSub" nutzt Pilze vom Typus Glänzender Lackporling, um biologisch abbaubare Leiterplatten herzustellen.
Die Herstellung dieser Leiterplatten erfolgt durch das Wachstum von Pilzfasern auf einem Nährmedium aus Holzspänen.

Nach dem Trocknen der Pilzfasern werden Kupferschichten aufgedampft und mit einem Laser bearbeitet, um Leiterbahnen zu erzeugen.

Die so hergestellten Leiterplatten sind belastbar und hitzebeständig, was durch Tests nachgewiesen wurde.

Elektronische Komponenten können auf diese Pilzleiterplatten wie auf herkömmlichen Leiterplatten montiert werden.

Die Pilzkomponenten können auf dem Haushaltskompost entsorgt werden, was zu einer nachhaltigen Entsorgung führt.